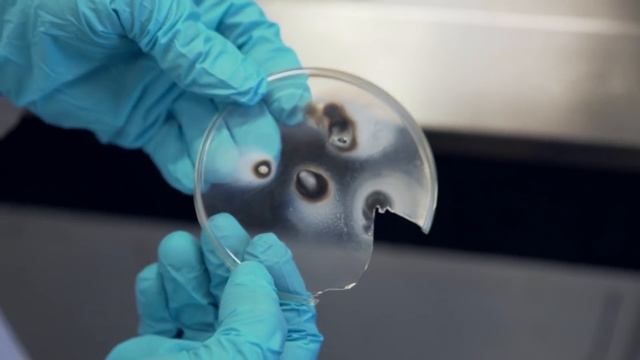
Arsenic - Periodic Table of Videos смотреть онлайн

Автор: Реакт и архитектура Flux Страница 11

reading like rory gilmore for a week

WARHAMMER 40,000 NEW EDITION & PERIAH NEXUS CINEMATIC REACTIONS!

Где можно купить Кроссовки Спанч Боб

NETinfo Digital Banking Platform

#Cypress - 2 | Cypress Folder not Generated After Installing Cypress | NATASA Tech

How to FIX FORTNITE MOBILE CONTROLS... @arjanbrussee
![[Blind Reaction] RWBY Thoughts 17, 18 & 19 смотреть онлайн](https://pic.rtbcdn.ru/video/96/4a/964a3cfe6a12c74d53678ca31ca52588.jpg)
[Blind Reaction] RWBY Thoughts 17, 18 & 19

Real Men Suck Dick Almonte Films| REACTION

PDF Editor Using Python (PikePDF) - Full Tutorial ?
![[MNTD] Node.js ¡En Vivo! - Real-Time Streaming Data - EventEmitter смотреть онлайн](https://pic.rtbcdn.ru/video/df/26/df268653e6de9b4c416d0ab1bdcb0df7.jpg)
[MNTD] Node.js ¡En Vivo! - Real-Time Streaming Data - EventEmitter

QUICKEST Twitch Clip Command with Streamer Bot (Posts to Discord)

Answering Beginner HTML and CSS Questions !

Cookiebot CMP implementation video

HOW TO SEE YOUR CONTROLLER INPUTS (Input Delay/Lag) ON FIFA 22

Cross Platform development with Blazor | .NET Conf Armenia 2023

꧁Sister location react to YOU CANT HIDE꧂

What are the 3 Core Web Vitals? LCP, FID, CLS & everything to know about Google's Core Web Vitals!

Venom vs Kraven in SpiderMan 2

Sans AUs react to random shit PART4 || ??&???? || ~ NightKiller – Cream – HorrorDust ~
![!You are Meme!~Warning blood,Communist~[Countryhuman AU]Part 3 : Remember our first meeting? смотреть онлайн](https://pic.rtbcdn.ru/video/02/01/0201fec5126fc36303e8ab411b2f3bd7.jpg)
!You are Meme!~Warning blood,Communist~[Countryhuman AU]Part 3 : Remember our first meeting?

Fighters react to Anderson Silva versus Julio Chavez Junior

Gameplay with Jump d-pad (?)
Arsenic - Periodic Table of Videos

The eminence shadow react to Cid Kagenou ll?manga spoilers?ll
За каждым успешным каналом стоит личность, идея и сотни часов кропотливого труда. Если вы здесь, значит, автор «Реакт и архитектура Flux» уже сумел зацепить ваше внимание своим уникальным стилем или подачей. А мы на RUVIDEO позаботились о том, чтобы вы могли изучить весь архив его работ в максимально комфортных условиях — без лишней суеты и преград.
Почему за работами канала «Реакт и архитектура Flux» так интересно наблюдать? Всё просто: это честный контент, который находит отклик в сердцах зрителей. На нашем ресурсе вы можете смотреть онлайн все видео любимого автора бесплатно и в хорошем качестве. Нам важно, чтобы вы видели каждую деталь и слышали каждый нюанс, поэтому мы используем только стабильные плееры из открытых источников Rutube.
Следите за новинками канала, пересматривайте старые шедевры и открывайте для себя новые грани творчества «Реакт и архитектура Flux». Мы постоянно обновляем ленту, чтобы у вас под рукой всегда были самые свежие выпуски. Никаких сложных регистраций — только вы и творчество, которое вдохновляет. Приятного вам путешествия по миру авторского контента на RUVIDEO!
Видео взято из открытых источников Rutube. Если вы правообладатель, обратитесь к первоисточнику.